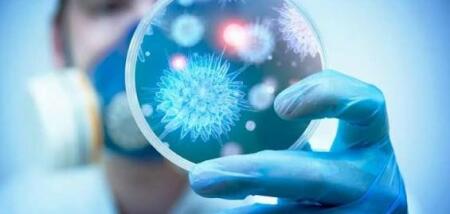

Новини Дніпра - головні Дніпровські новини






Новини Дніпра сьогодні
Зараз, у період пандемії COVID-19, складно вигадати причини, з яких не варто читати новини у Дніпрі. Звичайно, багато людей, як і раніше, вважають, що новини – упереджені, нудні та нав'язливі, їх занадто багато... і цей список можна продовжувати. Однак лише вивчення свіжої інформації про ситуацію в місті, країні та в усьому світі робить людей обізнаними та підготовленими до будь-яких ситуацій.
Звичайно, можна обійтися без пліток про знаменитостей, інформації про політичні перипетії та неприємні ситуації за кордоном. Фактично, без читання таких статей життя стане навіть кращим. Але якщо йдеться про важливі новини, які містять ключову інформацію для забезпечення безпеки жителів міста, то для сучасної людини її ігнорування неприпустимо.
Чому важливо знати останні новини Дніпра?
Сайт Дніпра 056.ua – це незалежний портал, який надає читачам лише об'єктивну інформацію про те, що відбувається у місті та за його межами. Журналісти збирають та публікують неупереджену інформацію, щоб користувачі сайту могли скласти власну думку про ту чи іншу ситуацію щодо всіх сфер життя міста.
Для зручності користувачів порталу всі публікації відсортовані. Якщо вас цікавлять статті на конкретну тему, ви можете скористатися нашим рубрикатором. Він містить такі рубрики:
- політика;
- економіка;
- культура;
- спортивні події;
- кримінал;
- влада;
- аналітика та інше.
Якщо ви бажаєте знайти певні статті, скористайтеся пошуком за ключовими словами. Події, що найбільш обговорюються в Дніпрі, сьогодні регулярно доповнюються фото і відео матеріалами з місць подій і оновлюються на підставі знову зібраних даних.
Цікавить погода у Дніпрі сьогодні? Журналісти порталу щодня публікують свіжу інформацію про останні зміни кліматичних умов. На сайті ви також можете дізнатись, якою буде погода у Дніпрі погодинно або на місяць вперед.
У місті згоріла будівля, і ви маєте унікальну інформацію про пожежу в Дніпрі, про яку ще не відомо іншим людям? Ви можете стати позаштатним журналістом сайту. Для цього достатньо повідомити новину, натиснувши кнопку в правому верхньому кутку. Заповніть всі необхідні поля, повідомте ваше ім'я та номер телефону, і головний редактор зв'яжеться з вами для уточнення інформації, що є у вас.
Читання новин зробить вас більш цікавим співрозмовником
У всіх нас бувають моменти, коли розмова з колегою, другом або членом сім'ї заходить у глухий кут, і нам залишається тільки гадати, про що говорити. Хоча новини часто не найлегша тема для розмови, вони можуть бути хорошим способом познайомитися з кимось і служать гарною відправною точкою, яка майже напевно буде пов'язана з безліччю тем. Обізнане розуміння поточних подій допоможе вам виділитися як критичний та серйозний мислитель, особливо у діловому середовищі.
Якщо вам набридло стежити за новинами, важливо пам'ятати, що не всі вони є політичними. Багато людей ухиляються від новин, бо не хочуть вплутуватися в драму та безладдя, які постійно відбуваються в українській політиці. Проте сцена новин набагато ширша, ніж те, що відбувається у Верховній Раді. Тому залишайтеся в курсі того, що відбувається у вашому місті, області, в Україні та за її межами, щоб залишатися свідомою та всебічно розвиненою людиною.